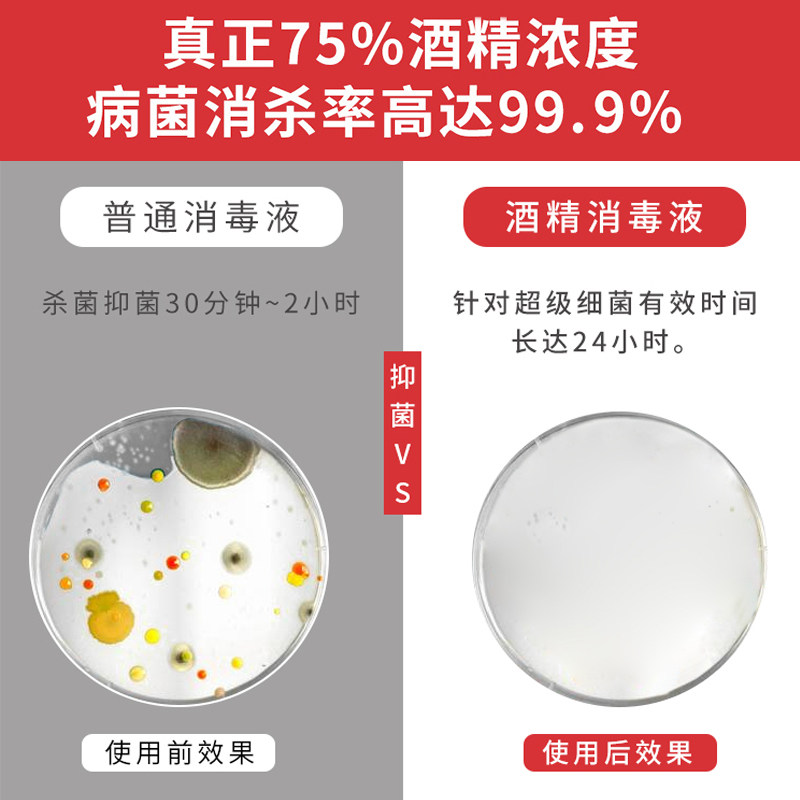

Дезинфекция алкоголя Renhe Disinfection влажный хлопок 75 градусов этанол медицинская стерилизация, чистая стерилизация, удаление стерилизатора

Цена: 421руб. (¥19.9)
Артикул: 614459239292
Цена указана со скидкой: 70%
Старая цена: 1395р.
Вес товара: ~0.7 кг. Указан усредненный вес, который может отличаться от фактического. Не включен в цену, оплачивается при получении.
Описание товараPHA+PGltZyBzcmM9Imh0dHBzOi8vaW1nLmFsaWNkbi5jb20vaW1nZXh0cmEvaTMvMjIwMTQyMzgxODg1OS9PMUNOMDF0ZzdORUoyRkpUTFRVdnBROF8hITIyMDE0MjM4MTg4NTkuanBnIiBhbGlnbj0iYWJzbWlkZGxlIj48aW1nIHNyYz0iaHR0cHM6Ly9pbWcuYWxpY2RuLmNvbS9pbWdleHRyYS9pNC8yMjAxNDIzODE4ODU5L08xQ04wMXA0MG52MTJGSlRMVjBzdDVTXyEhMjIwMTQyMzgxODg1OS5qcGciIGFsaWduPSJhYnNtaWRkbGUiPjxpbWcgc3JjPSJodHRwczovL2ltZy5hbGljZG4uY29tL2ltZ2V4dHJhL2kyLzIyMDE0MjM4MTg4NTkvTzFDTjAxb2RoTVJ2MkZKVExYSk9uUk1fISEyMjAxNDIzODE4ODU5LmpwZyIgYWxpZ249ImFic21pZGRsZSI+PGltZyBzcmM9Imh0dHBzOi8vaW1nLmFsaWNkbi5jb20vaW1nZXh0cmEvaTMvMjIwMTQyMzgxODg1OS9PMUNOMDEybmM3YnYyRkpUTFlJbk9BZl8hITIyMDE0MjM4MTg4NTkuanBnIiBhbGlnbj0iYWJzbWlkZGxlIj48aW1nIHNyYz0iaHR0cHM6Ly9pbWcuYWxpY2RuLmNvbS9pbWdleHRyYS9pMi8yMjAxNDIzODE4ODU5L08xQ04wMVZ1RHd6UDJGSlRMVDZpcG92XyEhMjIwMTQyMzgxODg1OS5qcGciIGFsaWduPSJhYnNtaWRkbGUiPjxpbWcgc3JjPSJodHRwczovL2ltZy5hbGljZG4uY29tL2ltZ2V4dHJhL2kyLzIyMDE0MjM4MTg4NTkvTzFDTjAxZ3FjMkd0MkZKVExVNUZqNDdfISEyMjAxNDIzODE4ODU5LmpwZyIgYWxpZ249ImFic21pZGRsZSI+PGltZyBzcmM9Imh0dHBzOi8vaW1nLmFsaWNkbi5jb20vaW1nZXh0cmEvaTMvMjIwMTQyMzgxODg1OS9PMUNOMDEwVU1HZXMyRkpUTExaSzdyTF8hITIyMDE0MjM4MTg4NTkuanBnIiBhbGlnbj0iYWJzbWlkZGxlIj48aW1nIHNyYz0iaHR0cHM6Ly9pbWcuYWxpY2RuLmNvbS9pbWdleHRyYS9pMS8yMjAxNDIzODE4ODU5L08xQ04wMU5JcnR1TjJGSlRMVTVIbnZEXyEhMjIwMTQyMzgxODg1OS5qcGciIGFsaWduPSJhYnNtaWRkbGUiPjxpbWcgc3JjPSJodHRwczovL2ltZy5hbGljZG4uY29tL2ltZ2V4dHJhL2kzLzIyMDE0MjM4MTg4NTkvTzFDTjAxWHhzd1Z4MkZKVExYSk9HQXpfISEyMjAxNDIzODE4ODU5LmpwZyIgYWxpZ249ImFic21pZGRsZSI+PGltZyBzcmM9Imh0dHBzOi8vaW1nLmFsaWNkbi5jb20vaW1nZXh0cmEvaTEvMjIwMTQyMzgxODg1OS9PMUNOMDFYZklvcDQyRkpUTFYwdGNydF8hITIyMDE0MjM4MTg4NTkuanBnIiBhbGlnbj0iYWJzbWlkZGxlIj48aW1nIHNyYz0iaHR0cHM6Ly9pbWcuYWxpY2RuLmNvbS9pbWdleHRyYS9pMi8yMjAxNDIzODE4ODU5L08xQ04wMXpYMUU4QzJGSlRMVTVIam1MXyEhMjIwMTQyMzgxODg1OS5qcGciIGFsaWduPSJhYnNtaWRkbGUiPjxpbWcgc3JjPSJodHRwczovL2ltZy5hbGljZG4uY29tL2ltZ2V4dHJhL2kxLzIyMDE0MjM4MTg4NTkvTzFDTjAxU3AyQXFZMkZKVExZMVRseXlfISEyMjAxNDIzODE4ODU5LmpwZyIgYWxpZ249ImFic21pZGRsZSI+PC9wPg==
Продавец:凯滨华家居专营店
Адрес:Хунань
Рейтинг:

Всего отзывов:0
Положительных:0
Добавить в корзину
- Информация о товаре
- Фотографии